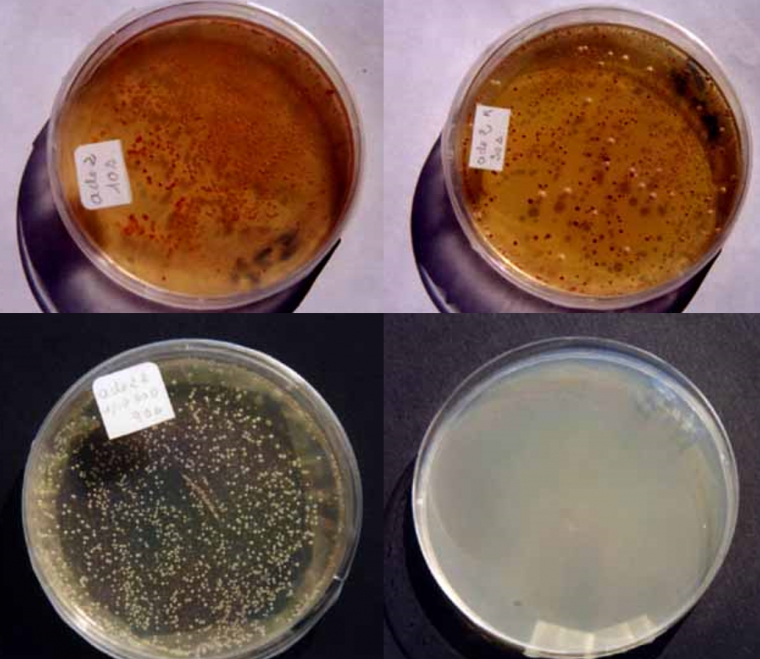
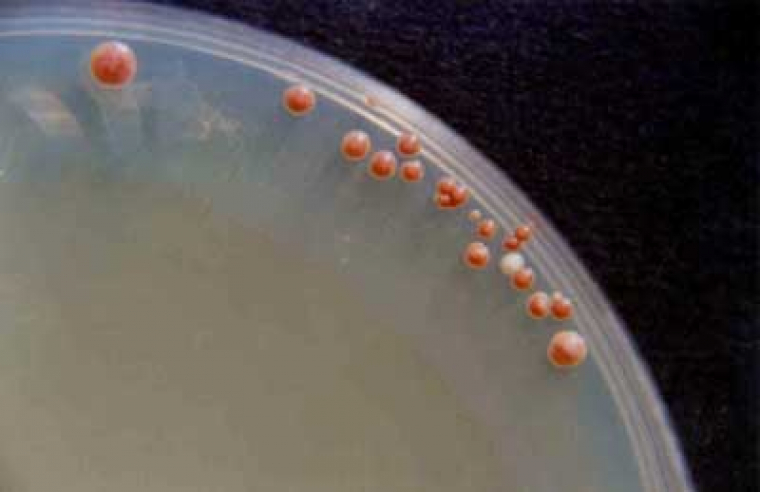

Protocole de mutagenèse chez la levure Saccharomyces cerevisiae. Analyse des mutants obtenus.
Présentation des levures Saccharomyces cerevisiae ade1 et ade2
Ces levures sont auxotrophes pour l’adénine, elles ne vivent donc pas sur un milieu minimum.
Sur un milieu complet, elles commencent la chaîne de réactions qui conduirait à la synthèse de l’adénine (Figure 1), mais il y a blocage par le gène ade 1 ou le gène ade 2, au niveau d’une molécule (phosphoribosylaminoimidazole), qui s’accumule et qui, au contact de l’air, devient rouge – d’où les colonies rouges.
Sur un milieu très particulier, très riche en adénine, les levures ade 1 et ade 2, font l’économie de toute la chaîne de réactions qui conduit à la synthèse de l’adénine – les colonies sont de couleur crème.
PRPP : phosphoribosyl pyrophosphate
PRA : 5-phosphoribosylamine
GAR : glycinamide ribotide ; FGAR : formyl glycinamide ribotide
FGAM : formyl glycinamidine ribotide
AIR : phosphoribosyl aminoimidazole
CAIR 5- amino 4-carboxyimidazole ribotide
SAICAR : 5-amino 4-succinocarboxyimidazole ribotide
AICAR : 5-amino 4-carboxamide imidazole ribotide
FAICAR : 5-formamido 4-carboxamide imidazole ribotide
IMP : inosine monophosphate
ADS : adénylo succinate
AMP : adénosine monophosphate
ATP : adénosine triphosphate
Toute l’expérimentation sera menée sur le milieu « complet », donc avec des colonies de couleur rouge.
Matériel
- Une boîte de levures – Saccharomyces cerevisiae ade 1 ou ade 2 – sur milieu solide pour ensemencement.
- Un tube à UV à filtre 4 W, 254 nm, avec socle de table.
- Une enceinte isolante en carton ou fabrication maison.
- Deux paires de lunettes anti UV 100 %.
- Deux écrans faciaux.
- Deux visières.
- Produits pour milieu complet :
- solide :
- 20 g extrait de malt ;
- 2 g extrait de levures ;
- 20 g glucose ;
- 15 g agar
- 1 L eau distillée.
- ou liquide (composition identique, mais sans agar).
- solide :
- Tubes.
- Boîtes de Petri.
- Ensemenceur.
- Vortex, si possible.
Protocole expérimental
- Travailler dans des conditions d’asepsie, près d’un bec Bunsen (éclairé avant et durant la manipulation).
- Prélever sur milieu solide, avec la pointe d’un cure-dents stérile, des levures ade 1 ou ade 2 ; prélèvement de la grosseur d’une tête d’épingle.
- Déposer ce prélèvement dans un tube qui contient 3 mL de milieu liquide complet.
- Agiter.
- Faire pousser une nuit à 30 °C.
- Le lendemain matin, agiter le tube puis diluer entre 1/3000 et 1/5000 (dans de l’eau distillée stérile).
- Prélever 200 mL de ce milieu dilué, étaler sur une boîte de Petri contenant du milieu complet solide stérile.
- Préparer ainsi une vingtaine de boîtes de Petri (même dilution et même volume pour tous les ensemencements).
- Deux boîtes ne seront pas exposées aux UV et seront des témoins.
- Exposer, aussitôt après, toutes les autres boîtes aux rayons UV.
- Se munir de gants, de lunettes anti UV et d’un écran facial avec visière.
- Placer une enceinte isolante sur la lampe à UV (enceinte soulevée au moment du passage des boites).
- Le tube UV a été allumé une heure avant l’utilisation et reste allumé durant toute la manipulation : énergie débitée constante.
- Durée d’exposition différente pour chaque boîte : par exemple 2 s ; 4 s ; 6 s ; 10 s ; 20 s ; 30 s ; 60 s ; 1 min ; 2 min ; 3 min, etc.
- Enlever le couvercle juste avant le passage aux UV (le plus près possible du tube).
- Placer la boîte sans couvercle sur le socle, sous le faisceau UV.
- Refermer aussitôt après exposition.
- Mettre dans l’étuve à 30 °C toutes les boîtes de Petri :
- Les boîtes témoins.
- Les boîtes exposées aux UV.
Résultats en 3 à 4 jours
Comparaison de la boîte témoin (colonies rouges) avec :
En haut à gauche, boîte ade 2 exposée 10 s : présence de colonies rouges, aucun changement
En haut à droite, boîte ade 2 exposée 30 s : nombreuses colonies rouges, quelques colonies crème (nouvelles colonies) et quelques petites colonies blanches (nouvelles colonies).
En bas à gauche, boîte ade 2 exposée 90 s : toutes les colonies sont blanches ou crème.
En bas à droite, boîte ade 2 exposée 150 s : une seule colonie blanche.
Présence de colonies rouges, de colonies crème (nouvelles colonies) et de colonies petites blanches (nouvelles colonies).
Interprétation par les élèves, explications
Ne pas oublier que ce sont des levures isolées qui ont été soumises à des rayons UV (dilution 1/3000 à 1/5000).
- Durée très faible d’exposition : aucun effet notable sur les levures.
- Durée d’exposition 30 à 90 s : présence de nouvelles levures (colonies petites blanches, colonies plus grosses crème).
- Durée d’exposition 150 s : une seule colonie, donc toutes les levures ont été tuées sauf une !
Puisque le nouveau caractère est apparu dans une colonie, il s’agit donc d’un caractère qui se transmet de cellule à cellule, donc la modification porte sur l’ADN. Il s’agit d’une mutation…
Puisque nous avons observé 2 types de nouvelles colonies, les rayons UV ont donc provoqué deux modifications différentes de l’ADN.
Discussion élargie à l’environnement :
- Action des rayons UV.
- Importance de la couche d’ozone dans l’absorption des rayons UV.
Remarques
Les résultats obtenus n’ont rien d’absolu, la durée d’exposition nécessaire varie avec le tube à UV utilisé, avec la distance levures-tube, etc.
Il faudrait utiliser des milieux sélectifs pour identifier précisément les différentes mutations obtenues :
- petites colonies blanches : levures qui ne peuvent plus respirer ;
- colonies crème : différentes mutations d’un gène situé en amont de ade 1 ou ade 2 dans la chaîne de biosynthèse de l’adénine ;
- etc.
Les rayons UV semblent moins puissants à la périphérie des boîtes : dans certaines boîtes, présence de colonies uniquement à la périphérie (voir la photo ci-dessous).
Il a semblé préférable de ne pas exposer les levures aux rayons UV devant les élèves (aucun risque pour les élèves).
Tout le matériel, tout le protocole expérimental et évidemment les résultats ont été présentés aux élèves, mais le tube à UV n’était pas allumé. Cela ne gêne en rien l’interprétation et la réflexion des élèves. Les élèves ont été très intéressés.
Conseils
- Travailler dans des conditions stériles.
- Ne pas ouvrir et refermer la boîte loin du tube à UV.
- Utiliser gants, lunettes anti UV 100 %, écran facial, car les rayons UV présentent un danger de brûlures ± irréversibles.
- Allumer le tube à UV une heure avant la manipulation.
- Laisser allumé durant toute la manipulation pour que l’énergie débitée soit constante.
- Faire un repère sur le socle pour placer successivement chaque boîte au même endroit (le faisceau UV n’est pas visible, on sent seulement de la chaleur sur la main).
Discussion
Didier Pol : « À mon avis, il est préférable d’étaler les cellules après les avoir irradiées. De cette façon, elles reçoivent une dose d’UV plus homogène. Si elles sont étalées avant l’irradiation, les différentes zones de la boîte ne reçoivent pas la même dose d’UV (distance à la lampe, réflexions éventuelles…). En outre, la mutagenèse est plus efficace en milieu liquide. Ceci explique les observations faites par l’auteur. »
Suzanne Garaix : « Je suis entièrement d’accord avec la réponse de Didier Pol. De mon côté je m’adresse à des élèves de seconde. Après présentation du protocole que j’ai utilisé et des résultats obtenus (Figure 3), je présente une boîte (Figure 5) où la plupart des levures a été tuée sauf à la périphérie.
Cette boîte permet, de la part des élèves, un raisonnement scientifique, une analyse critique des conditions expérimentales ; à savoir : le faisceau du rayonnement UV n’a pas atteint de façon homogène toute la surface de la boîte… Nous avançons dans la formation scientifique des élèves. »
Référence
Didier Pol. « Travaux pratiques de biologie des levures ». Collection Ellipses.